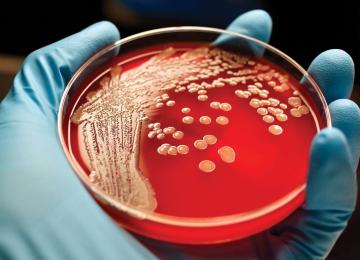

Over 400 people with heart failure are currently on the waitlist to receive transplants and around 200 patients are awaiting lung donations. Between 70 and 80 of the patients are in urgent need of…
People
<p>Iran people news, Read the latest news on Iran's society, including developments in sciences, education, universities, and students, along with stories about Iran health sector. </p>
- People
At the opening ceremony of a residential addiction treatment center for women in east Tehran Province, Vice President for Women and Family Affairs Shahindokht Molaverdi pointed out that women…
PeopleAn earthquake measuring 4.7 degrees on the Richter scale jolted Yasuj, the capital of the southwestern province of Kohgiluyeh-Boyer Ahmad, on Tuesday night. According to the Geophysics Institute…
PeopleA recent report by Iran’s Legal Medicine Organization indicates that last year (ended March 20), 30% of all cases of injury examined by legal medical experts were due to street brawls. The report…
PeopleAt least 48 people were injured after two metro trains collided in Tarasht Metro Station on Tehran Metro Line 2 on Tuesday, the Health Ministry announced. The accident occurred at 6:10 pm.
PeopleA terminal cancer patient who has been told he has just months to live has conquered Mount Everest.
Ian Toothill said he believes he is the first cancer patient to scale the world’s highest…
PeopleSince the beginning of the current year in March, police forces have seized 1.5 tons of illicit drugs in Iran’s southern province of Bushehr, said Arastu Torkaman Manesh, secretary of the…
PeopleThose who intentionally start wildfires will serve between three- and five-year prison terms, while those who carelessly cause fire in forests and other protected areas will be imprisoned for…
PeopleA Parisian woman is taking the French state to court for failing to protect her health from the effects of air pollution.
Clotilde Nonnez, a 56-year-old yoga instructor, says she has lived…
PeopleWith US President Donald Trump pulling the US out of the Paris climate accord, China and California signed an agreement on Tuesday to work together on reducing emissions, as the state’s governor…
PeopleA frontline park ranger from the Democratic Republic of Congo delivered an emotive testimony to Hong Kong legislators against the ivory trade in Hong Kong on Tuesday, as the city faces criticism…
PeopleSome 83,000 cubic meters of untreated wastewater and sewage are dumped into the coastal waters of Bandar Abbas in Hormozgan Province every day from the refineries and the satellite town of Hadish…
PeopleThe proposal for mandatory marriage and relationship education (MRE) is being reviewed at the Supreme Council of Cultural Revolution.
“Once the council approves the general outlines, it…
PeopleTwo villages, ‘Pesar Kanlou’ in Bojnurd and ‘Qarechai’ in Samalqan-Maneh, North Khorasan Province, will be relocated and reconstructed in other areas. They were recently hit by a strong earthquake…
PeopleBrain tumor is the most common type of cancer affecting children today after leukemia, said Dr. Azim Mehrvar, pediatric oncologist at MAHAK, the largest non-governmental organization in Iran that…
PeopleThe import of serums has been stopped in the country as Iran is currently meeting the local demand via domestically produced products, according to a statement by the Food and Drug Administration…
PeopleWhen children live through a contentious divorce by their parents, the fallout appears to harm their health for decades, even into adulthood, researchers said Monday.
The study involved 201…
PeopleDoctors are reporting unprecedented success from a new cell and gene therapy for multiple myeloma, a blood cancer that’s on the rise. Although it’s early and the study is small - 35 people - every…
PeopleThe rate of HIV/AIDS through sexual transmission has doubled over the past couple of years in Iran, according to officials.
“The rate of HIV/AIDS has seen an increase to 30% from the…
PeopleMore than 4,000 teaching and non-teaching staff will retire in Tehran city by the end of the current fiscal year in March 2018, said Alireza Kamrei, director general of Tehran’s Education…
PeopleAround 400,000 preschoolers will undergo health screening at hundreds of health centers across the country in summer, prior to their entry in the first grade of school in the new academic year on…
PeopleIranian nationals visiting Moscow, Saint Petersburg, Kazan and Sochi in Russia from June 17 to July 2 should register their arrival with the local immigration police within 24 hours, the Consulate…
PeopleRestoration of the towers of Roudkhan Castle, a historical site in the northern province of Gilan, will be complete by the end of the current Iranian year (ends March 20, 2018), the head of the…
PeopleA computer systems failure at British Airways last month that left tens of thousands of passengers stranded was caused by two human errors from a contractor, the CEO of the carrier’s parent…
PeopleAmerican citizens currently face no ban or obstacle for travelling to Iran and can apply for a visa without a problem, the president of Iran Tour Operators' Association said. …
People